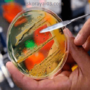
Что делать, если у беременной  сальмонеллез?

Сальмонеллез является острым инфекционным заболеванием с преимущественным поражением тонкого и толстого кишечника, причиной которого становится попадание в организм одного из видов сальмонеллы.
Сальмонеллез является острым инфекционным заболеванием с преимущественным поражением тонкого и толстого кишечника, причиной которого становится попадание в организм одного из видов сальмонеллы.
Лечение при сальмонеллезе у ребенка должно начинаться незамедлительно, ведь при этом заболевании в острой фазе часто наблюдаются быстро прогрессирующие расстройства водно-солевого обмена (рвота и понос), приводящие к острому обезвоживанию организма, которые очень опасны в детском возрасте.
Кроме того, при всасывании токсинов в организм развиваются признаки общей интоксикации – повышенная температура, головная боль, боль в животе, спазмы, что приводит к нарушениям общего самочувствия, отказу от пищи, нарушениям сна.
Лечение сальмонеллеза у детей обязательно должно проводиться под наблюдением опытного врача-инфекциониста, чаще всего требуется госпитализация пациента в стационар. Комплексное лечение этой кишечной инфекции включает в себя назначение соответствующей диеты, адекватное восполнение потерь жидкости, своевременное использование антибактериальных препаратов, активных в отношении сальмонеллы.
В острую стадию заболевания пациенту рекомендуют ограничение питания (полный голод в течение первых 12-24 часов после возникновения первых симптомов сальмонеллеза), одновременно с которым рекомендуют частый дробный прием жидкости для восполнения потерь, понесенных с рвотой и поносом.
Пациент должен принимать по 2 чайные ложки солевых растворов (регидрон, глюкосолан), травяных чаев, негазированной минеральной воды каждые 5-10 минут, а не стакан такого раствора один раз в 40-60 минут – при дробном введении жидкости шанс ее всасывания в кишечнике существенно увеличивается.
При расширении диеты рекомендуют начинать питание пациента с термически обработанной, протертой пищи, которая обладает обволакивающими свойствами, пищу дают небольшими порциями и дробно.
Никогда не следует принимать для лечения заболевания препараты, которые замедляют перистальтику кишечника (Имодиум, Лоперамид) – велик риск всасывания токсинов из просвета кишечника, что будет провоцировать ухудшение состояния пациента.
Необходимость применения антибактериальной терапии и выбор конкретного препарата определяются только врачом. При этом обязательно соблюдать рекомендованные дозировки препарата и продолжать лечение до конца курса – в противном случае заболевание часто переходит в хроническую форму.